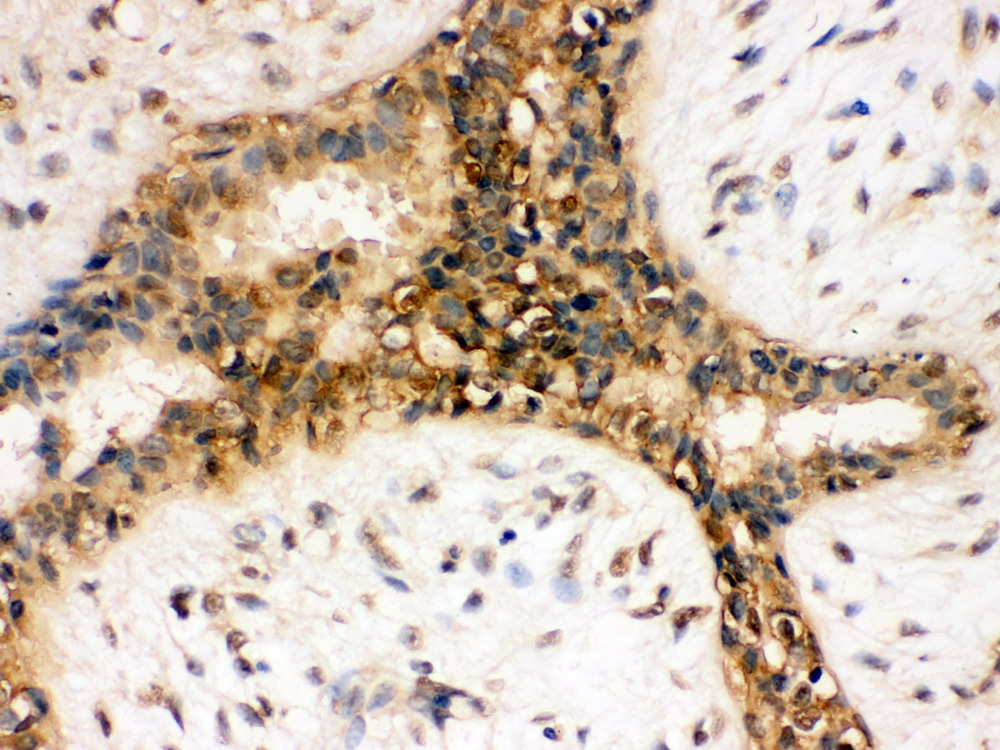

| Immunohistochemistry in paraffin section IHC-(P): | 1:50-400 |
| (Boiling the paraffin sections in 10mM citrate buffer,pH6.0,or PH8.0 EDTA repair liquid for 20 mins is required for the staining of formalin/paraffin sections.) Optimal working dilutions must be determined by end user. | |

IHC analysis of PI3 Kinase p110 Alpha/PIK3CA using anti-PI3 Kinase p110 Alpha/PIK3CA antibody (BA1353-1).
PI3 Kinase p110 Alpha/PIK3CA was detected in a paraffin-embedded section of human breast cancer tissue. Biotinylated goat anti-rabbit IgG was used as secondary antibody. The tissue section was incubated with rabbit anti-PI3 Kinase p110 Alpha/PIK3CA Antibody (BA1353-1) at a dilution of 1:200 and developed using Strepavidin-Biotin-Complex (SABC) (Catalog # SA1022) with DAB (Catalog # AR1027) as the chromogen.

IHC analysis of PI3 Kinase p110 Alpha/PIK3CA using anti-PI3 Kinase p110 Alpha/PIK3CA antibody (BA1353-1).
PI3 Kinase p110 Alpha/PIK3CA was detected in a paraffin-embedded section of human breast cancer tissue. Biotinylated goat anti-rabbit IgG was used as secondary antibody. The tissue section was incubated with rabbit anti-PI3 Kinase p110 Alpha/PIK3CA Antibody (BA1353-1) at a dilution of 1:200 and developed using Strepavidin-Biotin-Complex (SABC) (Catalog # SA1022) with DAB (Catalog # AR1027) as the chromogen.